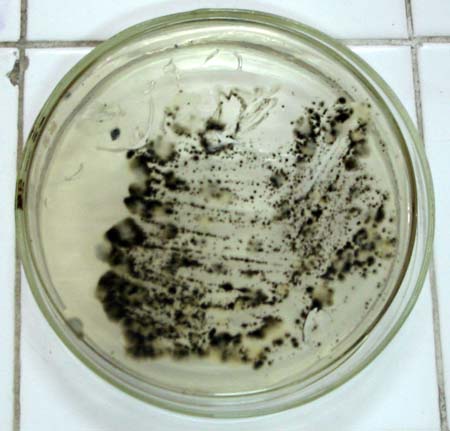

Cladosporium bantiana là một loại nấm sợi có màu vàng nâu, trong tự nhiên thường gặp trong đất, thực vật và là loại nấm ái nhiệt và có ái tính với hệ thần kinh. Vi nấm có thể gây bệnh ở người suy giảm miễn dịch và bệnh nhân ghép tạng. Trên thế giới vẫn còn ít trường hợp được báo cáo và điều trị đa số là thất bại. Chúng tôi báo cáo một trường hợp bệnh nhân apxe não do nhiễm không chỉ do Cladosporium batiana mà còn phối hợp với Candida albicans không có tiền sử mắc bệnh lý suy giảm miễn dịch hay ghép tạng trước đó.
Giới thiệu
Cladosporium bantiana hay Cladophialophora bantiana là một loại nấm sợi có vách ngăn có sắc tố màu vàng nâu có tính ái nhiệt và gây nhiễm ở hệ thần kinh trung ương, nhưng rất hiếm gặp và đường lây nhiễm chưa được xác định [1,2] . Bệnh được ghi nhận ở đối tượng suy giảm miễn dịch hoặc bệnh nhân ghép tạng. Các báo cáo gần đây đều ghi nhận chỉ có 21 trường hợp được báo cáo trên thế giới và điều trị thường không khả quan. Gần đây có một báo cáo của Mark K. Lyons ở Hoa Kỳ là điều trị thành côngvới Voriconazole [2].
Trong tự nhiên vi nấm hoại sinh có ở trong đất, thực vật, gỗ, bụi không khí và cũng là một tác nhân gây nhiễm ở phòng thí nghiệm. Vi nấm là nấm sợi có màu vàng nâu do melanin có ở thành tế bào nấm [1,5,6].
Báo cáo trường hợp
Bệnh nhân nam LVT 36 tuổi quê ở Thanh Hoá làm nghề khuân vác rau quả trái cây ở chợ TPHCM. Bệnh nhân không có tiền sử bệnh lý suy giảm miễn dịch hay ghép tạng trước đó, nhưng có tiền sử hút thuốc lá, thuốc lào và uống rượu từ lúc 15 tuổi. Năm 2002 bệnh nhân bị tai nạn xe máy gây chấn thương sọ não có máu tụ trong não nhưng kích thước bé chỉ điều trị nội khoa, vị trí khối máu tụ và các xử trí khác không khai thác được. Sau đó bệnh nhân được điều trị ổn định và sinh hoạt lại bình thường. Tuy nhiên thời gian gần đây bệnh nhân nhận thấy thỉnh thoảng mắt mờ thoáng qua chỉ trong giây lát, kèm theo đôi khi không điều khiển được động tác. Năm 2004 bệnh nhân bị động kinh, chưa điều trị gì. Từ đó đến nay lên 3 cơn, cơn gần nhất cách đây 1,5 năm. Cách đây khoảng 3 tháng bệnh nhân thấy yếu tay chân bên trái nên đi khám bệnh tại Trung tâm Y Khoa Medic Quận 10, TPHCM phát hiện thấy có thương tổn ở não, qua hình ảnh MRI kết luận: Tổn thương não vùng đỉnh phải. Có hiệu ứng choáng chỗ trên não thất bên bên phải và cấu trúc đường giữa. U não. CĐGPB: di căn não. Tổn thương ở thái dương bên phải sát sọ. Dập não cũ . Không có viêm xoang. Quá phát niêm mạc cuống mũi giữa và dưới 2 bên.Bệnh nhân được giới thiệu đến khám và điều trị bằng dao gamma ở Bệnh viện trường Đại học Y Dược Huế.
Vào viện ghi nhận: Bệnh nhân tỉnh táo không nhức đầu, không liệt, không nôn, và các dấu hiệu thần kinh cũng như cơ quan khác chưa phát hiện dấu bệnh lý. Bệnh nhân được cho làm các xét nghiệm thăm dò chức năng các cơ quan gan thận phổi tim đều chưa phát hiện dấu bệnh lý. Xét nghiệm HbsAg dương tính (+++). HIV âm tính. Chụp MRI sọ não cho thấy có thương tổn ở vùng đỉnh chẩm phải (hình 1).
 |
Hình 1: Thương tổn apxe não do nấm dưới hình ảnh MRI |
Bệnh nhân được chẩn đoán u não nguyên phát nghi do ký sinh trùng, không phải hình ảnh ung thư di căn não. Bệnh nhân tiếp tục được cho làm các xét nghiệm Ký sinh trùng huyết thanh chẩn đoán nang sán dây lợn cho kết quả âm tính. Sau khi được hội chẩn quyết định xử trí phẫu thuật bóc u làm giải phẫu bệnh và xét nghiệm nấm. Kết quả phẫu thuật bóc khối u hình chùm nho, dễ vỡ bên trong chứa dịch bã đậu, có ranh giới với tổ chức xung quanh, bóc u ít chảy máu, bóc hết u. Kết quả giải phẫu bệnh: Tổ chức bên ngoài là vỏ xơ, vùng trung tâm là tổ chức hoại tử vớimột ít đại thực bào và lympho. Chưa thấy tế bào bất thường. Kết luận: thương tổn apxe não có hình ảnh nghi nấm.
Xét nghiệm nấm tại khoa Ký sinh trùng bao gồm: Nghiền nhỏ bệnh phẩm bằng đũa thuỷ tinh vô khuẩn để nuôi cấy trên môi trường Sabouraud agar có Chloramphenicol ở nhiệt độ phòng và nhiệt độ 37 0 C sau đóxét nghiệm nấm trực tiếp bệnh phẩm với mực tàu và bệnh phẩm ngâm trong dung dịch KOH 30%, kết hợp với nghiền nhỏ bệnh phẩm soi trực tiếp sau khi nhuộm Giemsa. Kết quả xét nghiệm nấm trực tiếp kết luận: Nấm men có sợi giả kết hợp với nấm sợi có vách ngăn có sắc tố màu vàng nâu.(Hình 2).
 |
Hình 2. Xét nghiệm trực tiếp với KOH 30% |
Xét nghiệm với mực tàu không thấy hình ảnh nấm. Quá trình theo dõi định danh nấm như sau: Sau 48 giờ mẫu nuôi cấy mọc khuẩn lạc nấm men màu trắng sữa ở cả nhiệt độ phòng và 37 0 C nhưng vi nấm mọc tốt hơn ở nhiệt độ37 0 C , bên cạnh đó bắt đầu xuất hiện những khúm nấm có màu đen mọc ngay tại điểm nuôi cấy bệnh phẩm và cùng vị trí với khúm nấm men. Kết quả định danh nấm men: thử nghiệm sinh ống mầm dương tính với lòng trắng trứng, test urease âm tính, nuôi cấy trên môi trường thạch bột ngô tween 80 xác định Candida albicans ( hình 3).
 |
Hình 3. Ống mầm của C. albicans nuôi cấy từ bệnh phẩm |
Một tuần sau khúm nấm sợi có sắc tố đen mọc ở cả 2 nhiệt độ nhưng vẫn tốt hơn ở 37 0 CKết quả định danh nấm sợi: Cladosporium bantiana. Chẩn đoán xác định: thương tổn apxe não do nhiễm phối hợp nấm men Candida albicans và nấm sợi có màu Cladosporium bantiana. (hình 3,4).
 |
Hình 4:Nấm Cladosporum có sắc tố màu vàng nâu xen lẫn với nấm C. albicans được
nuôi cấy từ bệnh phẩm |
|
Hình 5: Nuôi cấy bệnh phẩm, Cladosporum và Candida mọc sau 24 giờ
và Cladosporummọc sau 1 tuần. |
Bệnh nhân được điều trị với Fluconazole truyền tĩnh mạch 400mg/ ngày trong 3 tháng. Nhưng sau 1 tuần điều trị kết quả không khả quan, hình ảnh MRI thương tiỉn lan rộng hơn. Bệnh nhân đang được tiếp tục theo dõi và điều trị.
Thảo luận
Cladosporium bantiana làmột loại nấm sợi có màu vàng nâu sống hoại sinh trong đất, gỗ, thực vật, vi nấm phân bố rộng rãi trên khắp thế giới [3]. Vi nấm có tính ái nhiệt và có tính hướng thần kinh trung ương, tuy nhiên đường lây nhiễm bệnh chưa được biết rõ[. Đường lây nhiễm có vẻ được chấp nhận là nhiễm bào tử nấm qua đường hô hấp và đến nãoqua đường máu. Ở bệnh nhân chúng tôi, có tiền sử chấn thương sọ não, làm việc trong môi trường có khả năng nhiễm bào tử nấm có lẽ cũng là một dấu hiệu gợi ý về đường lây nhiễm nấm, bởi bệnh nhân không có tiền sử bệnh lý suy giảm miễn dịch hay ghép tạng. Hơn nữa ở bệnh nhân chúng tôi nhiễm không chỉ Cladosporium bantiana mà còn có cả Candida albicans, những vi nấm này đều có thể gặp ở ống tai ngoài. Chúng tôi nêu những yếu tố này nhằm tăng thêm cứ liệu để khảo sát đường nhiễm nấm ở não.
Vi nấm gây apxe não cho đến nay chỉ có 21 trường hợp được báo cáo trên y văn thế giới [3]. Triệu chứng của bệnh là nhức đầu nhẹ và dấu thần kinh khu trú. Bệnh thường xảy ra ở nam nhiều hơn nữ với tỷ lệ là 3: 1 và độ tuổi ghi nhận là từ 6 đến 77 tuổi. Apxe não có thể một hay nhiều ổ với hình ảnh dễ thấy trên MRI. Mô bệnh học thương tổn gồm có mủ ở trung tâm và xung quanh là tổ chức hạt [6]. Xét nghiệm nấm trực tiếp với KOH 30% dễ dàng nhận thấy nấm sợi có vách ngăn có màu vàng nâu, với một số tế bào phình to và bào tử xếp thành chuỗi (hình). Trên tiêu bản nhuộm Giemsa cũng dễ dàng nhận diện vi nấm nhưng không quan sát được màu sắc của sợi nấm. Hình thể và định danh nấm được xác định khi nuôi cấy trên môi trường Sabouraud agar Cloramphenicol ở nhiệt độ phòng và 37 0 C với khúm nấm sợi có màu đen ở cả hai mặt recto và vecso, soi dưới kính hiển vi thấy rõ sợi nấm có màu vàng nâu với bào tử xếp thành chuỗi ( hình).
Về mặt điều trị, theo nhiều báo cáo trên thế giới thì điêù trị chủ yếu là phẫu thuật kết hợp điều trị thuốc kháng nấm. Hiệu quả của điều trị thuốc kháng nấm chưa được biết rõ. Có đến 15 bệnh nhân trong 20 bệnh nhân được báo cáo đã tử vong trong vòng 3 đến 11 tháng sau khi được điều trị phẫu thuật và thuốc kháng nấm đường toàn thân [5]. Theo Lyon Hoa kỳ, nuôi cấy vi nấm Cladosporium bantiana và làm kháng nấm đồ cho thấy nồng độ ức chế tối thiểu (MICs) của Amphotericin B, Fluconazole, Itraconazole, và Voriconazole lần lược là 0,5 µg/ml, 16µg/ml, 0,015µg/ml, 0,03µg/ml. Đồng thời ông cũng ghi nhận là đã điều trị thành công với Voriconazole [2]. Trong lúc đó Türker A ở Thổ Nhĩ Kỳ lại điều trị thành công với Fluconazole 400mg/ ngày trong vòng 3 tháng [4]. Mặc khác theo Rock ở Ireland thì nghiên cứu in vitro cho thấy vi nấm nhạy cảm với Amphotericine B , Itraconazole và Flucytocin, nhưng bệnh nhân của ông được điều trị với Amphotericine Bvà Flucytocin vẫn thất bại. Tuy nhiên bệnh nhân của chúng tôi được điều trị phẫu thật kết hợp với Fluconazole 400mg/ ngày trong 3 tháng, hiện tại sau 1 tuần điều trị, thương tổn trên MRI lan rộng hơn, bệnh nhân nhức đầu nhiều, và đang được theo dõi tiếp.
Tóm lại chúng tôi báo cáo một trường hợp apxe não do nấm Cladosporium bantiana kết hợp với Candida albicans đã được điều trị phẫu thuật và thuốc kháng nấm Fluconazole. Hiện tại bệnh đang được theo dõi. Đây là bệnh lý ít gặp trên thế giới, các hiểu biết về đường lây nhiễm nấm và điều trị chưa được hiểu biết đầy đủ và là trường hợp đầu tiên được báo cáo ở Việt nam.
Tài liệu tham khảo
1. Bioforma (2002), Les moisissures d’interet meïdical, Cahier de Formation, N.25. Bioforma, pp.114-115.
2. Lyon MK., Blair JE., Leslie KO., Successful treatment with voiconaole of fungal cerebral abscess due to Cladophialophora bantiana., Clin Neuro Neurosurg.2005 Oct; 107(6): 532-4.
3. Nadkani TD., Goel A., Shenoy A., Karapurkar AP.,Cladosporium bantiaum ( Trichoides) ìnection of the brain., J Postgad Med 1993; 39(1): 43-44.
4. Türker A., Altinors N., Aciduman A., Demiralp O., Uluoglu U., MRI findings and encouraging fluconazole treatment results of intracranial Cladosporium trichoidesonfection., Infection. 1995 Jan-Feb; 234(1):60-2.
5. Raut A., Muzumda D., Narlawar R., Nagar A., Ahmed N., Hira P., Cerebral abscess caused by Cladosporium bantiana infection., Neurol Med Chir ( Tokyo) 2003; 43: 413-415.
6. Roche M., Redmond RM., O’Neill S., Smyth E., A case of multiple cerebral bascesses due to infection with Cladophialophora bantiana., J Infect.2005 Dec; 51 (5): e285-8.